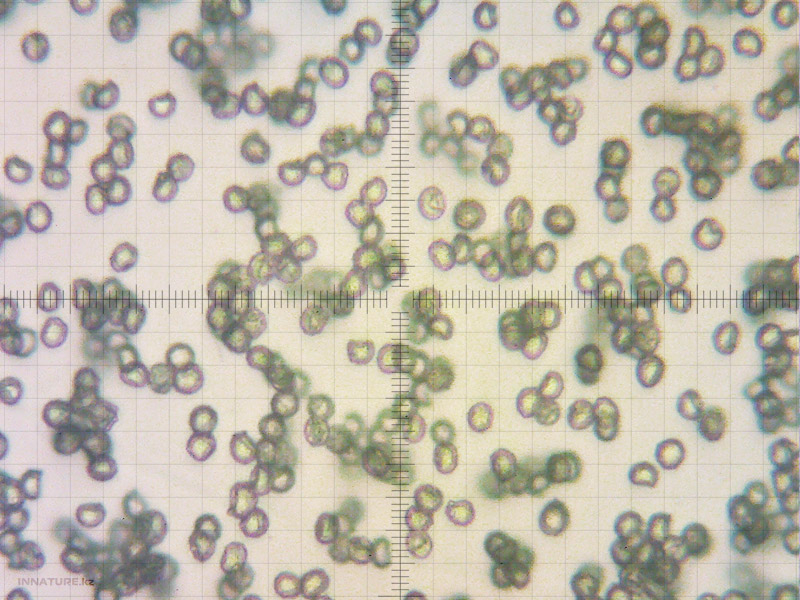
fungi_002_04.jpg

|
Последние статьи |
 |
 |
Бледная поганка |
 |
Паутинник заостренно... |
 |
Шампиньон красноватый |
 |
Сыроежка красная |
 |
Подгруздок зеленоват... |
 |
Подгруздок остроплас... |
 |
Сыроежка пламенно-ор... |
 |
Сыроежка кроваво-кра... |
 |
Сыроежка каштановая |
 |
Сыроежка розовоногая |
 |
Сыроежка девичья |
 |
Сыроежка мясистая |
 |
Сыроежка сереющая |
 |
Сыроежка пятнистая |
 |
Сыроежка пищевая |
 |
Сыроежка оливковая |
 |
Серый варан |
 |
Пилолистник чешуйчатый |
 |
Белый гриб настоящий |
 |
Белый гриб еловый |
 |
Авторизация |
 |
 |
Сейчас на сайте |
 |
 |
Друзья |
 |
 |
Информация |
 |
 |
Просмотр фото |
 |
| Фотоальбомы > Споры грибов > 0208072012 | << | >> |
222 0208072012
© Василий Федоренко
0208072012
оз. Каинды. Кунгей Алатау. Казахстан [08.07.2012]
Дата: 09/07/2012 18:21
Добавлено: arfey
Комментариев: 0
Рейтинг: Пусто
Количество просмотров: 1188
BBCode | миниатюра фото с увеличение по клику:
BBCode | полноразмерное фото с переходом по клику:
 |
Добавить комментарий |
 |
Пожалуйста, залогиньтесь для добавления комментария.
 |
Рейтинги |
 |
Рейтинг доступен только для пользователей.
Пожалуйста, залогиньтесь или зарегистрируйтесь для голосования.
Пожалуйста, залогиньтесь или зарегистрируйтесь для голосования.
Нет данных для оценки.









 грибы
грибы фотогалерея
фотогалерея флора
флора фауна
фауна птицы
птицы млекопитающие
млекопитающие пресмыкающиеся
пресмыкающиеся земноводные
земноводные бабочки
бабочки насекомые
насекомые рыбы
рыбы видео
видео казахстан
казахстан кулинария
кулинария статьи
статьи ссылки
ссылки о нас
о нас